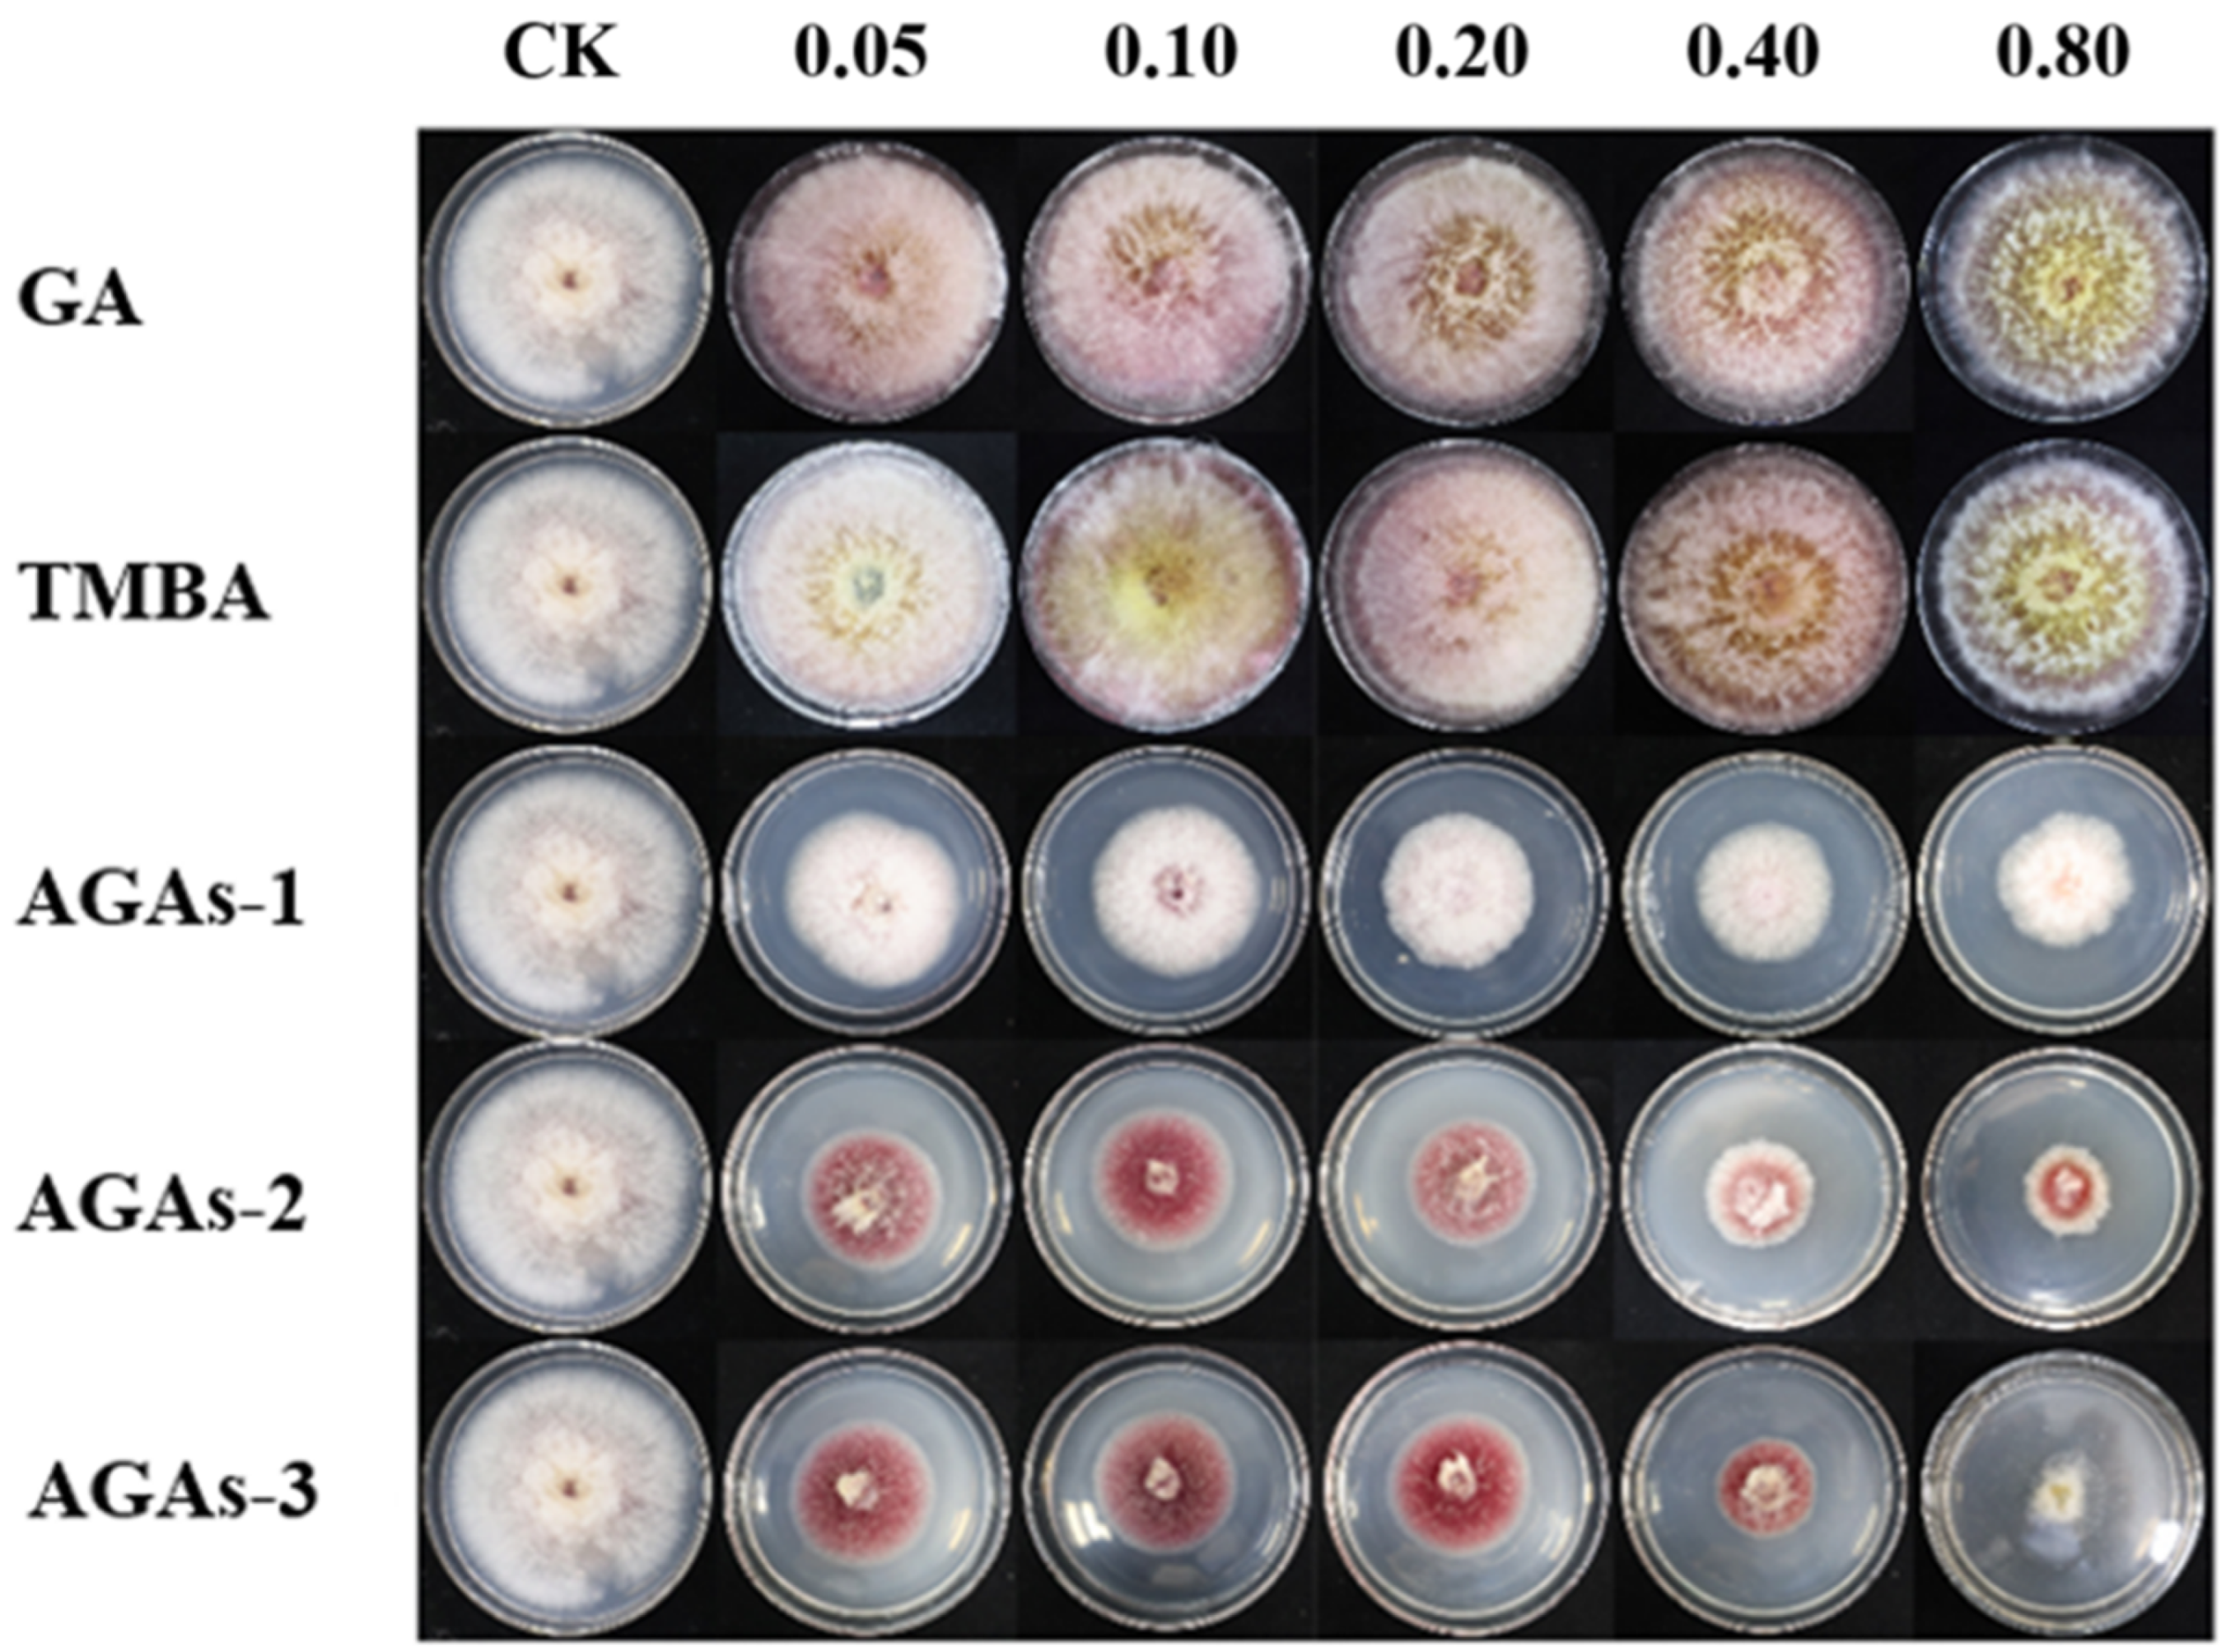
Molecules 29 01996 g004

Study on the Antifungal Activity of Gallic Acid and Its Azole Derivatives against Fusarium graminearum
Abstract
1. Introduction
2. Results and Discussion
2.1. Structural Characterization of GA and Its Derivatives
2.2. Inhibitory Effects of GA and Its Azole Derivatives on the Mycelial Growth Rate and Spore Germination of F. graminearum In Vitro
2.3. The Effect of Compound AGAs–3 on Mycelial Morphology
2.4. Field Efficacy Trials of GA and Its Azole Derivatives against F. graminearum In Vivo
2.5. Theoretical Calculation
3. Materials and Experimental Methods
3.1. Materials
3.2. Preparation of GA and Its Derivatives
3.2.1. Extraction and Purification of GA from Chestnut Leaves
3.2.2. Synthesis of Azole-Modified Gallic Acid Derivatives (AGAs1–3)
3.3. Characterization
3.4. Mycelial Growth Rate Experiment
3.5. In Vitro Antibacterial Activity Testing of Spore Germination
3.6. Methods of Sample Preparation for Scanning Electron Microscopy
3.7. Antifungal Activity of GA and Its Derivatives In Vivo
3.8. Theoretical Calculation
4. Conclusions
Supplementary Materials
Author Contributions
Funding
Institutional Review Board Statement
Informed Consent Statement
Data Availability Statement
Conflicts of Interest
References
- Escrivá, L.; Font, G.; Manyes, L. In vivo toxicity studies of fusarium mycotoxins in the last decade: A review. Food Chem. Toxicol. 2015, 78, 185–206. [Google Scholar] [CrossRef] [PubMed]
- Zhang, J.; Liu, Y.; Li, Q.; Zhang, X.; Shang, J.K. Antifungal activity and mechanism of palladium-modified nitrogen-doped titanium oxide photocatalyst on agricultural pathogenic fungi Fusarium graminearum. ACS Appl. Mater. Interfaces 2013, 5, 10953–10959. [Google Scholar] [CrossRef]
- Nottensteiner, M.; Absmeier, C.; Zellner, M. QoI fungicide resistance mutations in Alternaria solani and Alternaria alternata are fully established in potato growing areas in bavaria and dual resistance against SDHI fungicides is upcoming. Gesunde Pflanz. 2019, 71, 155–164. [Google Scholar] [CrossRef]
- Li, P.X.; Hua, Z.W.; Jiang, Z.N.; Jin, L.N.; Ai, Z.C.; Ling, Y.; Pei, D.C. Transformation of wheat thaumatin-like protein gene and analysis of reactions to powdery mildew and fusarium head blight in transgenic plants. Acta Agron. Sin. 2008, 34, 349–354. [Google Scholar] [CrossRef]
- Chen, C.H.; Chen, L.; Mao, C.Y.; Jin, L.G.; Wu, S.L.; Zheng, Y.F.; Cui, Z.D.; Li, Z.Y.; Zhang, Y.; Zhu, S.L. Natural Extracts for Antibacterial Applications. Small 2023, 20, 2306553. [Google Scholar] [CrossRef]
- Zhao, Z.M.; Shang, X.F.; Lawoe, R.K.; Liu, Y.Q.; Zhou, R.; Sun, Y.; Yan, Y.F.; Li, J.C.; Yang, G.Z.; Yang, C.J. Anti-phytopathogenic activity and the possible mechanisms of action of isoquinoline alkaloid sanguinarine. Pestic. Biochem. Physiol. 2019, 159, 51–58. [Google Scholar] [CrossRef] [PubMed]
- Lone, S.H.; Rehman, S.U.; Bhat, K.A. Synthesis of gallic-acid-1-phenyl-1H-[1,2,3] triazol-4-yl methyl esters as effective antioxidants. Drug Res. 2017, 11, 111–118. [Google Scholar] [CrossRef]
- Wang, P.; Liu, C.; Sanches, T.; Zhong, Y.; Liu, B.; Xiong, J.; Neamati, N.; Zhao, G. Design and synthesis of novel nitrogen-containing polyhydroxylated aromatics as HIV-1 integrase inhibitors from caffeic acid phenethyl ester. Bioorg. Med. Chem. Lett. 2009, 19, 4574–4578. [Google Scholar] [CrossRef]
- Dhingra, M.S.; Dhingra, S.; Chadha, R.; Singh, T.; Karan, M. Design, synthesis, physicochemical, and pharmacological evaluation of gallic acid esters as non-ulcerogenic and gastroprotective anti-inflammatory agents. Med. Chem. Res. 2014, 23, 4771–4788. [Google Scholar] [CrossRef]
- Rambabu, N.; Ram, B.; Dubey, P.K.; Vasudha, B.; Balram, B. Synthesis and biological activity of novel (E)-N’-(Substituted)-3,4,5-trimethoxybenzohydrazide analogs. Orient. J. Chem. 2017, 33, 226–234. [Google Scholar] [CrossRef]
- Zhang, H.Z.; Gan, L.L.; Wang, H.; Zhou, C.H. New progress in azole compounds as antimicrobial agents. Mini Rev. Med. Chem. 2017, 17, 122–166. [Google Scholar] [CrossRef] [PubMed]
- Peng, X.M.; Cai, G.X.; Zhou, C.H. Recent developments in azole compounds as antibacterial and antifungal agents. Curr. Top. Med. Chem. 2013, 13, 1963–2010. [Google Scholar] [CrossRef] [PubMed]
- Rezaei, Z.; Khabnadideh, S.; Zomorodian, K.; Pakshir, K.; Kashi, G.; Sanagoei, N.; Gholami, S. Design, synthesis and antifungal activity of some new imidazole and triazole derivatives. Arch. Der Pharm. 2011, 344, 658–665. [Google Scholar] [CrossRef] [PubMed]
- Sadeghpour, H.; Khabnadideh, S.; Zomorodian, K.; Pakshir, K.; Hoseinpour, K.; Javid, N.; Faghih-Mirzaei, E.; Rezaei, Z. Design, synthesis, and biological activity of new triazole and nitro-triazole derivatives as antifungal agents. Molecules 2017, 22, 1150. [Google Scholar] [CrossRef] [PubMed]
- Al Zahrani, N.A.; El-Shishtawy, R.M.; Asiri, A.M. Recent developments of gallic acid derivatives and their hybrids in medicinal chemistry: A review. Eur. J. Med. Chem. 2020, 204, 112609. [Google Scholar] [CrossRef] [PubMed]
- Sherin, L.; Sohail, A.; Shujaat, S. Time-dependent AI-Modeling of the anticancer efficacy of synthesized gallic acid analogues. Comput. Biol. Chem. 2019, 79, 137–146. [Google Scholar] [CrossRef] [PubMed]
- Oliveira, C.; Bagetta, D.; Cagide, F.; Teixeira, J.; Amorim, R.; Silva, T.; Garrido, J.; Remião, F.; Uriarte, E.; Oliveira, P.J.; et al. Benzoic acidderived nitrones: A new class of potential acetylcholinesterase inhibitors and neuroprotective agents. Eur. J. Med. Chem. 2019, 174, 116–129. [Google Scholar] [CrossRef] [PubMed]
- Locatelli, C.; Rosso, R.; Santos-Silva, M.C.; de Souza, C.A.; Licínio, M.A.; Leal, P.; Bazzo, M.L.; Yunes, R.A.; CreczynskiePasa, T.B. Ester derivatives of gallic acid with potential toxicity toward L1210 leukemia cells. Bioorg. Med. Chem. 2008, 16, 3791–3799. [Google Scholar] [CrossRef]
- Siti, H.N.; Kamisah, Y.; Kamsiah, J. The role of oxidative stress, antioxidants and vascular inflammation in cardiovascular disease (a review). Vasc. Pharmacol. 2015, 71, 40–56. [Google Scholar] [CrossRef]
- Fathi, M.A.A.; El-Hafeez, A.A.A.; Abdelhamid, D.; Abbas, S.H.; Montano, M.M.; Abdel-Aziz, M. 1,3,4-oxadiazole/chalcone hybrids: Design, synthesis, and inhibition of leukemia cell growth and EGFR, Src, IL-6 and STAT3 activities. Bioorg. Chem. 2019, 84, 150–163. [Google Scholar] [CrossRef]
- Li, Q.; Fang, H.; Wang, X.; Hu, L.; Xu, W. Novel cyclic-imide peptidomimetics as aminopeptidase N inhibitors. Design, chemistry and activity evaluation. Part I. Eur. J. Med. Chem. 2009, 44, 4819–4825. [Google Scholar] [CrossRef] [PubMed]
- Queiroz, M.F.; Sabry, D.A.; Sassaki, G.L.; Rocha, H.A.O.; Costa, L.S. Gallic aciddextran conjugate: Green synthesis of a novel antioxidant molecule. Antioxidants 2019, 8, 478. [Google Scholar] [CrossRef] [PubMed]
- Murumkar, P.R.; Ghuge, R.B. Vicinal Diaryl Oxadiazoles, Oxazoles, and Isoxazoles. In Vicinal Diaryl Substituted Heterocycles; Elsevier: Amsterdam, The Netherlands, 2018; pp. 277–303. [Google Scholar] [CrossRef]
- Khabnadideh, S.; Rezaei, Z.; Ghasemi, Y.; Montazeri-Najafabady, N. Antibacterial activity of some new azole compounds. Anti-Infect. Agents 2012, 10, 26–33. [Google Scholar] [CrossRef]
- Schenone, S.; Brullo, C.; Bruno, O.; Bondavalli, F.; Ranise, A.; Filippelli, W.; Rinaldi, B.; Capuano, A.; Falcone, G. New 1,3,4-thiadiazole derivatives endowed with analgesic and anti-inflammatory activities. Bioorg. Med. Chem. 2006, 14, 1698–1705. [Google Scholar] [CrossRef] [PubMed]
- Kini, S.G.; Bhat, A.R.; Bryant, B.; Williamson, J.S.; Dayan, F.E. Synthesis, antitubercular activity and docking study of novel cyclic azole substituted diphenyl ether derivatives. Eur. J. Med. Chem. 2009, 44, 492–500. [Google Scholar] [CrossRef] [PubMed]
- Mir, F.; Shafi, S.; Zaman, M.; Kalia, N.P.; Rajput, V.S.; Mulakayala, C.; Mulakayala, N.; Khan, I.A.; Alam, M. Sulfur rich 2-mercaptobenzothiazole and 1,2,3-triazole conjugates as novel antitubercular agents. Eur. J. Med. Chem. 2014, 76, 274–283. [Google Scholar] [CrossRef] [PubMed]
- Ding, Z.; Ni, T.; Xie, F.; Hao, Y.; Yu, S.; Chai, X.; Jin, Y.; Wang, T.; Jiang, Y.; Zhang, D. Design, synthesis, and structure-activity relationship studies of novel triazole agents with strong antifungal activity against Aspergillus fumigatus. Bioorg. Med. Chem. Lett. 2020, 30, 126951. [Google Scholar] [CrossRef]
- Mahmoudi, Y.; Badali, H.; Hashemi, S.M.; Ansari, M.; Fakhim, H.; Fallah, M.; Shokrzadeh, M.; Emami, S. New potent antifungal triazole alcohols containing N-benzylpiperazine carbodithioate moiety: Synthesis, in vitro evaluation and in silico study. Bioorg. Chem. 2019, 90, 103060. [Google Scholar] [CrossRef]
- Wani, M.Y.; Ahmad, A.; Aqlan, F.M.; Al-Bogami, A.S. Azole based acetohydrazide derivatives of cinnamaldehyde target and kill Candida albicans by causing cellular apoptosis. ACS Med. Chem. Lett. 2020, 11, 566–574. [Google Scholar] [CrossRef]
- Doğan, İ.S.; Sarac, S.; Sari, S.; Kart, D.; Gökhan, Ş.E.; Vural, I.; Dalkara, S. New azole derivatives showing antimicrobial effects and their mechanism of antifungal activity by molecular modeling studies. Eur. J. Med. Chem. 2017, 130, 124–138. [Google Scholar] [CrossRef]
- Li, B.; Zhang, D.; Zhang, Y.; Jiang, D.; Li, S.; Lei, W.; Wang, H.; Lin, F. Synthesis and evaluation of novel benzene-ethanol bearing 1, 2, 4-triazole derivatives as potential antimicrobial agents. Med. Chem. Res. 2017, 26, 44–51. [Google Scholar] [CrossRef]
- Shaik, A.; Bhandare, R.R.; Palleapati, K.; Nissankararao, S.; Kancharlapalli, V.; Shaik, S. Antimicrobial, antioxidant, and anticancer activities of some novel isoxazole ring containing chalcone and dihydropyrazole derivatives. Molecules 2020, 25, 1047. [Google Scholar] [CrossRef] [PubMed]
- Faria, J.V.; Vegi, P.F.; Miguita, A.G.C.; dos Santos, M.S.; Boechat, N.; Bernardino, A.M.R. Recently reported biological activities of pyrazole compounds. Bioorg. Med. Chem. 2017, 25, 5891–5903. [Google Scholar] [CrossRef] [PubMed]
- Zheng, X.N.; Ma, Z.N.; Zhang, D.W. Synthesis of Imidazole-Based Medicinal Molecules Utilizing the van Leusen Imidazole Synthesis. Pharmaceuticals 2020, 13, 37. [Google Scholar] [CrossRef] [PubMed]
- Li, X.; Li, Y.; Xu, W. Design, synthesis, and evaluation of novel galloyl pyrrolidine derivatives as potential anti-tumor agents. Bioorg. Med. Chem. 2006, 14, 1287–1293. [Google Scholar] [CrossRef] [PubMed]
- Abdel-Aziz, M.; Gamal-Eldeen, A.M. Synthesis and screening of anti-cancer, antioxidant, and anti-inflammatory activities of novel galloyl pyrazoline derivatives. Pharmaceut. Biol. 2009, 47, 854–863. [Google Scholar] [CrossRef]
- Zhou, Z.Y.; Zhou, S.G.; Zhang, X.R.; Zeng, S.H.; Xu, Y.; Nie, W.Y.; Zhou, Y.F.; Xu, T.; Chen, P.P. Quaternary Ammonium Salts: Insights into Synthesis and New Directions in Antibacterial Applications. Bioconjug. Chem. 2023, 34, 302–325. [Google Scholar] [CrossRef] [PubMed]
- Nadagouda, M.N.; Vijayasarathy, P.; Sin, A.; Nam, H.; Khan, S.; Parambath, J.B.M.; Mohamed, A.A.; Han, C. Antimicrobial activity of quaternary ammonium salts: Structure-activity relationship. Med. Chem. Res. 2022, 31, 1663–1678. [Google Scholar] [CrossRef]
- Zeng, Q.-L.; Jiang, Y.-Z.; Jiang, S.; Yu, B. Study on the bactericidal effect of quaternary ammonium salt disinfectants and their bactericidal persistence on the surface of objects. Chin. J. Disinfect. 2018, 35, 818–821. [Google Scholar]
- Zhang, W.; Cheng, C.; Wang, R.; Peng, F.; Du, H.; Zheng, Z.; Hou, W.; Yang, Y.; Wang, X.; Deng, Y. Graphene oxide modification enhances the activity of chitosan against Fusarium graminearum in vitro and in vivo. Int. J. Biol. Macromol. 2022, 219, 1112–1121. [Google Scholar] [CrossRef]
- Mosey, N.J.; Hu, A.; Woo, T.K. Ab initio molecular dynamics simulations with a HOMO–LUMO gap biasing potential to accelerate rare reaction events. Chem. Phys. Lett. 2003, 373, 498–505. [Google Scholar] [CrossRef]
- Tan, P.; Liu, S.Y.; Zhou, T.P.; Sun, D.M.; Peng, C.J.; Du, B.; Ren, D.; Yang, X.L.; Wang, Z.Y. Synthesis of Gallic Acid Derivatives and Their Antibacterial Activities. J. Xihua Univ. (Nat. Sci. Ed.) 2018, 37, 108–112. [Google Scholar] [CrossRef]
- Shao, J.; Pei, Z.; Jing, H.; Wang, L.; Jiang, C.; Du, X.; Jiang, C.; Lou, Z.; Wang, H. Antifungal activity of myriocin against Fusarium graminearum and its inhibitory effect on deoxynivalenol production in wheat grains. Physiol. Mol. Plant Pathol. 2021, 114, 101635. [Google Scholar] [CrossRef]
- Vanti, G.L.; Masaphy, S.; Kurjogi, M.; Chakrasali, S.; Nargund, V.B. Synthesis and application of chitosan-copper nanoparticles on damping off causing plant pathogenic fungi. Int. J. Biol. Macromol. 2020, 156, 1387–1395. [Google Scholar] [CrossRef] [PubMed]
- Xian, L.M.; Hu, Y.; Li, L.; Sun, Z.X.; He, X.Y.; Li, T. Discussion on the Correspondence between the Types and Identification Methods of Wheat Fusarium Head Blight Resistance. Prog. Biotechnol. 2021, 11, 554. [Google Scholar]
- Hu, W.J.; Gao, D.R.; Jiang, W.; Liao, S.; Ma, H.B.; Zhang, X.Y. Analysis of Fusarium head blight resistance and genotype of 71 wheat varieties in the Huanghuai wheat region. J. Triticeae Crops 2021, 41, 1479–1486. [Google Scholar]
- Frisch, M.J.; Trucks, G.W.; Schlegel, H.B.; Scuseria, G.E.; Robb, M.A.; Cheeseman, J.R.; Scalmani, G.; Barone, V.; Mennucci, B.; Petersson, G.A.; et al. Gaussian 09 Revision, D.01; Gaussian, Inc.: Wallingford, CT, USA, 2013. [Google Scholar]
- Becke, A.D. Density-functional thermochemistry. III. The role of exact exchange. J. Chem. Phys. 1993, 98, 5648–5652. [Google Scholar] [CrossRef]
- Lee, C.; Yang, W.; Parr, R.G. Development of the Colle-Salvetti correlation-energy formula into a functional of the electron density. Phys. Rev. B 1988, 37, 785–789. [Google Scholar] [CrossRef] [PubMed]
- Hehre, W.J. Ab Initio Molecular Orbital Theory. Acc. Chem. Res. 1976, 9, 399–406. [Google Scholar] [CrossRef]
- Humphrey, W.; Dalke, A.; Schulten, K. VMD: Visual molecular dynamics, J. Mol. Graph. 1996, 14, 33–38. [Google Scholar] [CrossRef]
- Lu, T.; Chen, F. Multiwfn: A multifunctional wavefunction analyzer. J. Comput. Chem. 2012, 33, 580–592. [Google Scholar] [CrossRef] [PubMed]

| Compound | Slope ± Standard Error | EC50 (mg/mL) (95% Confidence Interval) |
|---|---|---|
| GA | 2.47 ± 1.42 | 10.62 (0.10–1089.02) |
| TMBA | 2.45 ± 1.42 | 10.92 (0.10–1153.72) |
| AGAs–1 | 1.07 ± 0.04 | 0.64 (0.57–0.72) |
| AGAs–2 | 0.33 ± 0.03 | 0.49 (0.39–0.61) |
| AGAs–3 | 1.40 ± 0.26 | 0.42 (0.27–0.66) |
| Treatment | Number of Surveyed Plants | Disease Incidence (%) | Disease Severity Index | Control Efficacy (%) |
|---|---|---|---|---|
| CK | 94 | 92.55 | 76.064 | - |
| GA | 95 | 95.23 | 30.015 | 55.13 |
| TMBA | 88 | 94.32 | 29.545 | 56.73 |
| AGAs–1 | 94 | 90.43 | 31.383 | 58.74 |
| AGAs–2 | 95 | 74.74 | 23.684 | 68.86 |
| AGAs–3 | 99 | 78.79 | 21.212 | 72.11 |
Disclaimer/Publisher’s Note: The statements, opinions and data contained in all publications are solely those of the individual author(s) and contributor(s) and not of MDPI and/or the editor(s). MDPI and/or the editor(s) disclaim responsibility for any injury to people or property resulting from any ideas, methods, instructions or products referred to in the content. |
© 2024 by the authors. Licensee MDPI, Basel, Switzerland. This article is an open access article distributed under the terms and conditions of the Creative Commons Attribution (CC BY) license (https://creativecommons.org/licenses/by/4.0/).
Share and Cite
Zheng, Y.; Geng, Y.; Hou, W.; Li, Z.; Cheng, C.; Wang, X.; Yang, Y. Study on the Antifungal Activity of Gallic Acid and Its Azole Derivatives against Fusarium graminearum. Molecules 2024, 29, 1996. https://doi.org/10.3390/molecules29091996
Zheng Y, Geng Y, Hou W, Li Z, Cheng C, Wang X, Yang Y. Study on the Antifungal Activity of Gallic Acid and Its Azole Derivatives against Fusarium graminearum. Molecules. 2024; 29(9):1996. https://doi.org/10.3390/molecules29091996
Chicago/Turabian StyleZheng, Yilin, Yuqi Geng, Wenlong Hou, Zhe Li, Caihong Cheng, Xiuping Wang, and Yuedong Yang. 2024. "Study on the Antifungal Activity of Gallic Acid and Its Azole Derivatives against Fusarium graminearum" Molecules 29, no. 9: 1996. https://doi.org/10.3390/molecules29091996
APA StyleZheng, Y., Geng, Y., Hou, W., Li, Z., Cheng, C., Wang, X., & Yang, Y. (2024). Study on the Antifungal Activity of Gallic Acid and Its Azole Derivatives against Fusarium graminearum. Molecules, 29(9), 1996. https://doi.org/10.3390/molecules29091996

